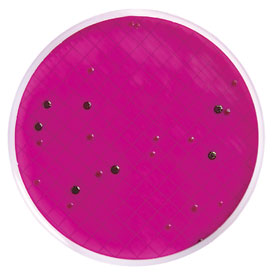
Coliform colonies in mEndo agar (note green metallic sheen) Membrane filtration
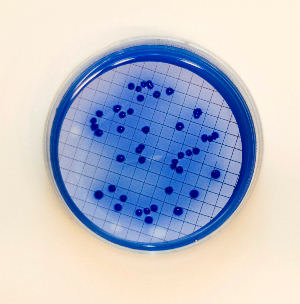
Fecal coliform colonies in mFC agar plates (membrane filtration)

Bacteriological analysis of water is one component of drinking water quality analysis. Water is screened for the presence of fecal contamination by testing for the presence of an indicator microorganism.
Indicator microorganisms are ones that have the following properties:
- The microorganism is not found in water and will be present in the water only when a contamination event has occurred; and
- The density of the microorganisms present should be proportional to the degree of contamination.
E.coli which is a normal flora present in the intestine of humans and animals meets the above requirements so detection of E.coli and/or related bacteria termed “coliforms” is done using many different techniques as a part of a bacteriological analysis of water. One of the techniques is the membrane filtration method.

Membrane filtration method
In this method, water from different samples is passed through a membrane filterwith a pore size of 0.45 µm, and the membrane is incubated on an agar plate. Bacterial cells trapped on the membrane will grow into colonies that can be counted, and the bacterial density of the water samples can be calculated. Depending on the source of the water different filtration volumes of water samples are used.
Table 1: Typical sample volumes for membrane filtration analysis
Note:
- Small volumes should be added to the filtration apparatus together with a minimum of 9 ml of sterile diluent to ensure adequate dispersal across the surface of the filter membrane
- 1.0, 0.1, 0.01, and 0.001-ml volumes are filtered after first preparing serial dilutions of the sample.
Since large volumes of the sample can be filtered, the membrane filtration technique can detect the presence of a very low number of bacteria. However, the turbidity of the water may limit the volume of samples that is practical to filter. High numbers of background bacteria or toxic substances if present may interfere with the test and result in underestimation of the density of coliforms.
Total coliforms and fecal coliforms
They are the members of the family Enterobacteriaceae. Coliforms may include bacteria of the following genera: Escherichia, Enterobacter, Klebsiella, Citrobacter, andSerratia. Fecal coliforms are the subset of total coliforms which are found within the digestive tract and shed through feces. Fecal coliforms can ferment lactose with the production of acid and gas at 44.5°C within 24 hours. They are also said to be thermotolerant coliforms as they can grow at a higher temperature. Bacteria belonging to the genera Escherichia and Enterobacterare considered fecal coliforms.
Detection of total coliforms and fecal coliforms
Total coliforms and fecal coliforms are detected using selective and differential culture medium. For the detection of total coliforms mEndo agar LES is used and for fecal coliforms, mFC agar is used. On mEndo agar, coliforms will form red colonies with a metallic sheen and on mFC agar, fecal coliforms will form dark blue colonies.Â
Detection of total coliforms using mEndo agar LES
This medium contains lactose and a pH indicator (that changes color when acid is produced due to fermentation of lactose).  Membrane filter is incubated at 35°C for 22-24 hours for the detection of total coliforms.
Coliforms typically will produce a metallic (golden) sheen, which is due to the extensive production of aldehydes and acid from the fermentation of lactose.
Atypical total coliforms colonies appear as dark red, mucoid, or have a dark center but without a metallic sheen. E.coli will form colonies with a metallic sheen.
Detection of fecal coliforms using mFC agar
This medium contains bile salts which inhibit other bacteria except enteric. It also contains rosolic acid which inhibits bacteria other than fecal coliforms. Aniline blue is used as a pH indicator which gives blue color in acidic pH.
 Membrane filter is incubated at 44.5°C for 22-26 hours in mFC agar for the detection of fecal coliforms.
Fecal coliforms form blue colonies in this medium (acid is produced due to the fermentation of lactose). Â E.coli will form flat dark blue colonies.
Materials required
Apparatus
- Incubator(s) or water-bath(s)
- Membrane filtration apparatus, complete with a vacuum source (electrically operated pump, hand pump, or aspirator) and suction flask
- Autoclave for sterilizing prepared culture media
- Boiling pan or bath (if filtration apparatus is to be disinfected in boiling water between uses)
- Laboratory balance
- Racks for bottles of prepared culture media and dilution water. These must fit into the autoclave
- Distilling apparatus with storage capacity for at least 5 liters of distilled water
- Refrigerator for storage of prepared culture media
- Hot-air sterilizer for sterilizing pipettes and glass or metal Petri dishes
- Thermometer for checking the calibration of incubator or water bath
- Pipette cans for sterilizing pipettes
- Boxes for Petri dishes for use in a hot-air sterilizer
- Reusable bottles for culture media
- Measuring cylinders, capacity 100 ml, and 250 ml
- Reusable pipettes, glass, capacity 1 ml, and 10 ml
- Bottles to contain 9-ml volumes of buffered dilution water
- Flasks for the preparation of culture media
- Wash-bottle
- Blunt-edged forceps
- Pipette bulbs
- Spatula
- Container for used pipettes
- Brushes for cleaning glassware (several sizes)
- Fire extinguisher and first-aid kit
- Miscellaneous tools
- Waste bin
Consumables
- Methanol for disinfecting filtration apparatus using formaldehyde gas (unnecessary in the laboratory, but essential if analyses are done in the field). It is essential to use methanol. Ethanol or methylated spirits cannot be substituted.
- Membrane filters, 0.45 µm pore size, and diameter appropriate for the filtration apparatus being used and complete with absorbent pads.
- Disinfectant for cleaning laboratory surfaces and a container for discarded pipettes.
- Culture media (mEndo Agar LES and mFC Agar).
- Phosphate-buffered dilution water.
- Petri dishes, glass or aluminum (reusable) or plastic (disposable).
- Polyethylene bags for wrapping Petri dishes if a dry incubator is used.
- Magnifying lens (as an aid to counting colonies after filters are incubated).
- Wax pencils for labeling Petri dishes.
- Autoclave tape.
- Detergent for cleaning glassware and laboratory equipment.
- Positive control sample (100 ml of water with a 5 ml of a 1:100 dilution of an overnight culture of E.coli)
- Negative control sample (sterile water)
- Water samples to be tested: Volume of water needed for testing.Â
Water sample collection Precautions
- Water sample must be collected in a sterile bottle
- Water sample must be representative of the supply from which it is taken.
- Contamination of the sample must be avoided during and after sampling.
- The sample should be tested as promptly as possible after collection.
- If there is a delay in the examination of the sample, it should be stored at a temperature between 0 and 10°C.
Procedure of membrane filtration technique
- Sterilise the tips of the blunt-ended forceps in a flame and allow them to cool.
- Carefully remove a sterile membrane filter from its package, holding it only by its edge.
- Place the membrane filter in the filter apparatus, and clamp it in place. (If the apparatus has been disinfected by boiling, ensure that it has cooled down before inserting the membrane filter.)
Mix the sample by inverting its container several times. Pour or pipette the desired volume of sample into the filter funnel. This volume should normally be chosen in the light of previous experience, but suggested volumes are given in Table 1. If the volume to be filtered is less than 10 ml, it should be made up to at least 10 ml with sterile diluent so that the sample will be distributed evenly across the filter during filtration.- Apply a vacuum to the suction flask and draw the sample through the filter; disconnect the vacuum.
Dismantle the filtration apparatus and remove the membrane filter using the sterile forceps, taking care to touch only the edge of the filter.
Remove the lid of a previously prepared mENDO agar LES plate and place the membrane, grid side uppermost, onto the agar. Lower the membrane, starting at one edge in order to avoid trapping air bubbles between membrane and agar**.**Mark the petri dish with the sample number or other identification. The sample volume should also be recorded. Use a wax pencil or waterproof pen when writing on Petri dishes.- Repeat procedure (1 to 8) with the same volume, but place membranes on mFC plates.
- Incubate mEndo agar LES plates at 35 ± 0.5°C for 22 – 24 hours and mFC plates at 44.5 ± 0.2°C for 22 to 26 hours, all lid side down. In order to maintain the temperature within such a narrow range, a water bath is typically used for incubation of the mFC agar plates. These plates are placed in watertight plastic bags and then submerged in the water bath.
Day 2 (24 hours later):
After 22 – 24 hours, remove the mEndo agar LES plates from the 35°C incubator and count the colonies that are dark red, mucoid, have a dark center or (more typically) produce a metallic sheen. These are considered to be total coliform colonies.
2. From the mEndo agar LES plates, choose two total coliform colonies that are isolated on the membrane and confirm that they are Gram-negative rods and non-spore formers.
3.
After 22 to 26 hours, remove the mFC agar plates from the 44.5°C incubator and count the colonies that have any blue color. These are considered to be fecal coliform colonies**.**
References and further reading
- Water Quality Monitoring – A Practical Guide to the Design and Implementation of Freshwater Quality Studies and Monitoring Programmes (WHO)
- Brian Forster, Catalina Arango Pinedo. 2015. Bacteriological examination of waters: membrane filtration protocol. American Society for Microbiology (ASM)
- Manual for Bacteriological Analysis of Natural Water Supply Sources in Disaster Situations. Pan American Health Organization (PAHO)
- Pelczar MJ, Chan ECS, Krieg NR (2007). Microbiology. 5th edn. Tata McGraw-Hill.